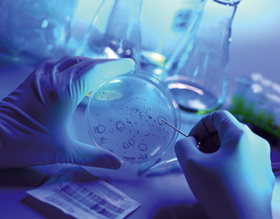

|
|
|
![[Meldungen]](../../../images/fun2001/balken/balken_meldungen.gif)
Leibniz-Preis
Der Gottfried Wilhelm Leibniz-Preis ist der höchstdotierte deutsche Förderpreis. Ziel des 1985 eingerichteten Programms der Deutschen Forschungsgemeinschaft ist es, die Arbeitsbedingungen herausragender Wissenschaftlerinnen und Wissenschaftler zu verbessern, ihre Forschungsmöglichkeiten zu erweitern, sie von administrativem Arbeitsaufwand zu entlasten und ihnen die Beschäftigung besonders qualifizierter Nachwuchswissenschaftler zu erleichtern. Für den Preis können Wissenschaftlerinnen und Wissenschaftler aus allen Fachgebieten nominiert werden. Benannt wurde er nach Gottfried Wilhelm Leibniz (1646–1716). Der deutsche Philosoph und Universalgelehrte leitete mit seiner formal-deduktiven Logik das mathematische Zeitalter ein. Neben Newton begründete Leibniz die Differentialrechnung. Ferner entwickelte er das binäre Zahlensystem mit den Ziffern 0 und 1, das heute in der Computertechnik wichtig ist.
GW

Erfahrungen Schizophrener besser verstehen
„Er sei gesegnet, fuhr er fort, mit der Gabe und der Bürde der Prophezeiung. Wenn die Menschen nur zuhören wollten...“ Das von dem schizophrenen Thomas in Wally Lambs Roman „Früh am Morgen beginnt die Nacht“ geforderte Verstehen ist ein noch ungelöstes Problem in der Psychotherapie. Denn wie weit kann und soll Verstehen in solchen Fällen gehen? Die Psychotherapeutin Jutta G. Schäfer untersuchte am Fachbereich Psychologie, ob und unter welchen Bedingungen schizophrene Erfahrungen verstehbar und sinnhaften Deutungen zugänglich sind. In fünf Interviews mit Patienten, versuchte sie nicht nur deren Sichtweisen zu begreifen, sondern gleichzeitig ihre eigenen Verständnisgrenzen zu analysieren. Schizophrene Erfahrungen sind Nichtbetroffenen weitestgehend fremd. Zwischen Fremdem und Eigenem bestehen kulturell und sozial geprägte Grenzen. Das Verständnis für das Fremde kann zwar auf psychotherapeutischer Seite erweitert, aber nicht vollständig erreicht werden, so Schäfer, da sonst die Unterscheidung zwischen Fremdem und Eigenem nicht mehr möglich wäre und einen Identitätsverlust zur Folge hätte. Ein weiterer wesentlicher Aspekt des Verstehens ist die Distanz zu den Interviewpartnern und zur eigenen Perspektive, um eine verzerrungsfreie Wahrnehmung zu gewährleisten und die Übertragung eigener Erfahrungen auf den Betroffenen zu vermeiden. Letztendlich ist Verstehen für Jutta Schäfer ein „Balanceakt zwischen Überwindung und Anerkennung von Differenzen“. Für die Begegnung mit Patienten mit schweren Psychosen bedeutet das, die Persönlichkeit und die psychotischen Erfahrungen zu akzeptieren. Therapeuten haben die Aufgabe, „dem Kranken Schutz zu gewähren und ihn gleichzeitig als handelnde Person mit Eigenverantwortung anzuerkennen“ betont sie.
MM

Pharmazeuten werben 1,62 Millionen Euro ein
Das Institut für Pharmazie der Freien Universität kooperiert mit dem englischen Pharma-Unternehmen Pfizer Ltd. Es soll innovative Arzneiformen mit kontrollierter Wirkstofffreigabe entwickeln. Die Kooperation mit Pfizer ist auf drei Jahre angelegt und wird mit 1,62 Millionen Euro finanziert. Der Schwerpunkt der Zusammenarbeit liegt auf der Entwicklung neuer Retard- und Depotarzneiformen. Sie verzögern die Freigabe des Arzneistoffes im Körper. Damit werden die Effektivität des Arzneistoffes und der Therapieerfolg entscheidend beeinflusst.
Bekannt geworden sind Roland Bodmeier und sein Forscherteam von der Abteilung Pharmazeutische Technologie der Freien Universität für ihre Arbeiten zu oralen und injizierbaren Depotarzneimitteln. Die Wissenschaftler werden mit Pfizers Forschungslabors in Sandwich (England), Kalamazoo und Groton (beide USA) zusammenarbeiten. Pfizer ist der größte Arzneimittelhersteller der Welt. Das Pharma-Unternehmen entwickelt neue Medikamente für eine Vielzahl von Krankheiten, wie zum Beispiel Herz-Kreislauf-Mittel, Antibiotika, Schmerzmittel, Psychopharmaka oder Antidementiva.
Foto: UNICOM

Laser für die Feuerwehr
Eine Erfindung aus der Freien Universität Berlin macht die Einsätze der Feuerwehr sicherer. Ein handlicher Laser ist in der Lage, unbekannte Materialien schnell zu bestimmen, zu bohren und zu schneiden. Der Physiker Ludger Wöste ließ sich das Verfahren gemeinsam mit Jean-Pierre Wolf von der Universität Lyon patentieren.
Oftmals sind Ursache und Art eines Feuers nicht sofort zu klären, vor allem dann nicht, wenn der Ort schwer zugänglich ist. Giftige Gase können entweichen oder Stoffe durch falsche Brandbekämpfung explodieren. Das birgt große Gefahren für die Löschteams. Hier bietet die Erfindung von Ludger Wöste und Jean-Pierre Wolf die Möglichkeit, sofort und gefahrlos Materialanalysen aus sicherer Entfernung durchzuführen.
Bei herkömmlichen Laseranalysen konnte der Laserstrahl nur in einem bestimmten Punkt gehalten werden. Wollte man mehrere Materialien unterschiedlicher Größe und Art analysieren, musste der Sammelpunkt des Lichtstrahls jedes Mal neu positioniert werden. Die Forscher sind nun in der Lage, die Laserleistung über eine haarfeine und variierbare Strecke wirksam zu machen: das Plasma-Filament. Dieses Lichtbündel kann aus großer Entfernung in den Brandherd geschossen werden. Die starke Laserenergie verdampft und ioni-siert das unbekannte Material. Seine Spuren können anschließend durch ein Spektrometer und ein Fernrohr genau bestimmt werden. Thomas Rode
Kontakt:
Prof. Ludger Wöste, Institut für Experimentelle Physik der Freien Universität Berlin, Telefon: 030/838-55566,
E-Mail: woeste@physik.fu-berlin.de

940.000 Euro für geistes-wissenschaftliche Forschung
Die Deutsche Forschungsgemeinschaft (DFG) hat jüngst die Einrichtung einer Forschergruppe „Selbstzeugnisse in transkultureller Perspektive“ am Fachbereich Geschichts- und Kulturwissenschaften beschlossen. Insgesamt bewilligte sie 14 interdisziplinäre und überregionale neue Forschergruppen. Die DFG stellt ihnen für die kommenden drei Jahre über 20 Millionen Euro zur Verfügung. Unter den 14 Forschergruppen befinden sich nur zwei geisteswissenschaftliche, eine davon an der FU. Die von ihr bearbeiteten sieben Projekte werden mit insgesamt 940.000 Euro gefördert.
Das Team um Prof. Dr. Claudia Ulbrich untersucht Selbstzeugnisse wie Tagebücher, Briefe, Reiseberichte oder Autobiographien. Lange hat man Selbstzeugnisse für eine typisch europäische Form des Schreibens gehalten. Die Gruppe „Selbstzeugnisse in transkultureller Perspektive“ wählt einen neuen Ansatz. Sie untersucht Selbstzeugnisse aus verschiedenen, auch außereuropäischen Kulturen, Ländern und Zeiten als Formen kultureller und sozialer Praxis, um Unterschiede und Gemeinsamkeiten herauszuarbeiten. An der Forschergruppe sind Historiker, Japanologen und Turkologen beschäftigt. Ihr Ziel ist es, das Schreiben über das eigene Leben vom 16. bis zum 20. Jahrhundert zu untersuchen und die in den Texten formulierten Personenkonzepte herauszuarbeiten. Dies geschieht am Beispiel von Themen wie „Gastfreundschaft in Selbstzeugnissen des 16. Jahrhunderts“, „Selbstzeugnisse im Dreißigjährigen Krieg“, „Selbstzeugnisse eines tatarischen Weltreisenden und Intellektuellen im 20. Jahrhundert“.
Kontakt:
Prof. Dr. Claudia UlbrichTelefon: 030 / 838-54380
E-Mail: ulbrich@zedat.fu-berlin.de

600.000 Euro für Kitaqualität
Das Team des Kleinkindpädagogen Wolfgang Tietze hat 600.000 Euro erhalten, um bundesweit Erzieherinnen von Kindertagesstätten nach den neuesten Qualitätsstandards zu beraten und zu schulen. Gefördert wird das Projekt im Rahmen der Nationalen Initiative „Qualitätssicherung in Tagesseinrichtungen für Kinder“, das 1999 vom Bundesministerium für Familie, Senioren, Frauen und Jugend ins Leben gerufen wurde, um die Qualität von Kindertageseinrichtungen zu verbessern.

Foto: UNICOM
Die Initiative besteht aus zwei Teilen: der Entwicklungs- und Erprobungsphase sowie der Verankerungsphase. In der Entwicklungsphase, an der die FU-Kleinkindpädagogen bereits mitgewirkt haben, wurden grundlegende Qualitätskriterien erstellt. Sie beziehen sich auf Prozesse der Betreuung, Bildung und Erziehung von Kindern im Alter von null bis sechs Jahren. Der erarbeitete Kiterienkatalog diente anschließend dem Programm „Qualität in Kindertageseinrichtungen“ als Grundlage für vorbildliche Beispiele in der pädagogischen Arbeit mit Kindern. Dieser Katalog wurde von der Pädagogischen Qualitäts-Informations-Systeme gGmbH (PädQUIS), einem Kooperationsinstitut der Freien Universität Berlin, entwickelt, und bundesweit in über 250 öffentlichen und freien Kitas erprobt.
ee

Viel Geld für Regen
Die Deutsche Forschungsgemeinschaft (DFG) fördert ein Projekt der FU-Meteorologen: Etwa 120.000 Euro stellt sie für zwei Jahre bereit, um „Wechselwirkungen im Klimasystem der Erde“ erforschen zu lassen. Die Meteorologen um Professor Ulrich Cubasch untersuchen, welche dynamischen Parameter die Niederschlagsprognosen beeinflussen. Die Vorhersagbarkeit des Niederschlags ist von herausragender wirtschaftlicher und sozialer Bedeutung. Allerdings ist die quantitative Niederschlagsvorhersage noch immer unzureichend, denn die Meteorologen wissen zu wenig über den Wasserkreislauf und seine Auswirkungen auf das Wetter. Auch sind die Beobachtungen und die Vorhersagemodellen noch mangelhaft verknüpft. Das Ziel der FU-Forscher ist es, die Aussagefähigkeit der verschiedenen Prognosemodelle zu verbessern. Der Deutsche Wetterdienst wird ihnen zu diesem Zweck sein operationelles Vorhersagesystem zur Verfügung zu stellen. Langfristig dienen die Forschungen also dazu, das Wetter besser vorhersagen zu können.
|
|
|
|
![[Freie Universität Berlin]](../../../images/fun2001/img/fu_logo_rot_160px.gif)
![[FU-Nachrichten - Zeitung der Freien Universität Berlin]](../../../images/fun2001/img/fu_nachrichten_schriftzug.gif)